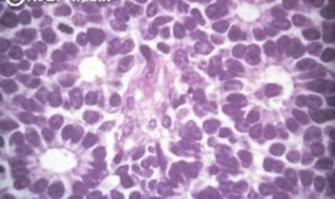

Jaime Torres OFTALMOLOGÍA
Trastornos del campo visual Neuritis óptica
Definición
Uveítis anterior (Iridociclitis)
Tumores orbitarios primarios
Hemangioma capilar
Hemangioma cavernoso
Rabdomiosarcoma
Neurofibroma
Tumores de glándula lacrimal
Tumores orbitarios metastásicos
Tumores intraoculares primarios
Glaucoma crónico (Ángulo abierto)
Glaucoma agudo (Ángulo cerrado) Glaucoma congénito
Í
Celulitis periorbitaria (preseptal) Celulitis orbitaria (postseptal) Dacrioadenitis Dacriocistitis Dacrioestenosis 01 Orzuelo Chalazión Blefaritis Ptosis
Patología de anexos: Párpados
de anexos: Sistema lagrimal
adultos Conjuntivitis en recién nacido
Uveítis intermedia
Uveítis posterior (Coriorretinitis) pág. 11 02 pág. 17 03 pág. 21
Epiescleritis Escleritis
NDICE
Ectropión
Patología
Conjuntivitis en
(Parsplanitis)
Queratitis
Glaucoma secundarios
Epidemiología Etiología Diagnóstico Tratamiento
Retinopatía diabética Retinopatía hipertensiva Oclusión de la arteria central de la retina Oclusión de la vena central de la retina Degeneración macular asociado con la edad Desprendimiento de retina Trauma ocular cerrado Trauma ocular abierto Fractura de órbita Quemaduras químicas Miopía Hipermetropía Astigmatismo Presbicia Ambliopía Patología inflamatoria de órbita 04 pág. 23 Patología de la conjuntiva 05 pág. 27 Patología de córnea y esclera 06 pág. 31 Patología de la Úvea 07 pág. 35 Glaucoma 08 pág. 39 Patología de la retina 09 pág. 47 10 pág. 49 11 pág. 53 Neuroftalmología Lesiones oculares traumáticas Catarata 12 pág. 55 Defectos de refracción (Ametropías) 13 pág. 59
PATOLOGÍA DE ANEXOS: PÁRPADOS 01.
Orzuelo
DEFINICIÓN
Inflamación aguda de los folículos de las pestañas (glándulas Zeis o de Meibomio)
ETIOLOGÍA
Principalmente Staphylococcus aureus, rara vez Streptococcus
Mayor incidencia en personas con acné vulgar y diabetes mellitus.
Recuerda
S. aureus también es la causa más frecuente de blefaritis bacteriana, forúnculo, foliculitis e hidradenitis supurativa.
GLÁNDULA ZEIS (sebácea)
CLASIFICACIÓN
Orzuelo externo: inflamación de la glándula de Moll (sudorípara) o de Zeis (sebácea) en el borde del párpado.
Orzuelo interno: inflamación de la glándula de Meibomio (sebácea); generalmente visible en la conjuntiva palpebral


GLÁNDULA MEIBOMIO (sebácea)
GLÁNDULA MOLL (sudorípara)
DIAGNÓSTICO
Nódulo doloroso, eritematoso en el párpado (ENAM 2018)
TRATAMIENTO
La mayoría de los orzuelos son autolimitados y se resuelven espontáneamente después de 1 a 2 semanas.
Compresa tibia y masaje Tratamiento con antibióticos tópicos (Gentamicina, amoxicilina, eritromicina)
www.qxmedic.com PAG. 7
Figura 2. Inflamación eritematosa nodular local de la parte medial del párpado superior. Este hallazgo es consistente con una inflamación bacteriana aguda de una glándula en el borde palpebral (orzuelo).
Figura 1. Glándulas del párpado: en el borde externo tenemos a la glándula de Zeis y Moll, en la parte interna se encuentra la glándula de Meibomio
Chalazion


DEFINICIÓN
Inflamación granulomatosa crónica de las glándulas sebáceas (meibomio)(ENAM 2011, ENAM 2008)

ETIOLOGÍA
Mala higiene de los párpados, estrés o inmunodeficiencia
Condiciones sistémicas: tuberculosis, rosácea, dermatitis seborreica
Anormalidades anatómicas locales: complicaciones de blefaritis crónica, trauma o después de una cirugía.
DIAGNÓSTICO
Nódulo indoloro, elástico, firme y crónico (de crecimiento lento) en el párpado(ENAM 2018)
El chalazión persistente o recurrente puede ser un signo de carcinoma sebáceo (carcinoma de la glándula de Meibomio).

TRATAMIENTO
Esteroides intralesionales (triamcinolona) < 4 mm Incisión y legrado si el nódulo mide > 4 mm
Infecciosa (S. Aureus) Obstructiva (obstrucción de la glándula)
Zeizz/Moll o Meibomio
Inflamación, edema e hiperemia en el borde palpebral
Lavado, calor, antibiótico (Cloranfenicol, bacitracina, eritromicina)
Meibomio
Nódulo, no edema, no eritema
<4 mm: Triamcinolona
>4 mm: Incisión y curetaje
www.qxmedic.com OFTALMOLOGÍA PAG. 8
ORZUELO CHALAZION Agudo Crónico Doloroso No doloroso
Figura 3. Esta es la apariencia típica de un chalazión, que se desarrolla debido a la obstrucción y la posterior inflamación granulomatosa de la glándula de Meibomio.
Blefaritis
DEFINICIÓN
La blefaritis es una afección palpebral común que se presenta como una inflamación escamosa crónica y / o recurrente de los márgenes del párpado.
ETIOLOGÍA
Estafilococos (patógeno causante más común)
Parasitarias: Demodex sp.
Enfermedades sistémicas: rosácea, atopia y dermatitis seborreica
CLASIFICACIÓN
Anterior: Blefaritis bacteriana o dermatitis seborreica
Posterior: rosácea
DIAGNÓSTICO
Placas costrosas, escamosas y / o depósitos aceitosos en el borde del párpado y las pestañas (ENAM 2018)
♦ La formación de costras suele representarse en una enfermedad seborreica
♦ Una colección en forma de anillo alrededor de las pestañas (collarete) es típica de la enfermedad estafilocócica
♦ Una colección tubular suave en la base de la pestaña es típica de Demodex.
TRATAMIENTO
Higiene del margen del párpado Antibióticos tópicos, en enfermedad grave
Ptosis
DEFINICIÓN

Caída total o parcial de uno o ambos párpados superiores
ETIOLOGÍA
Congénito
Miogénico
♦ Causa más común de ptosis congénita


♦ Malformación del músculo elevador del párpado superior Neurogénico: inervación defectuosa del párpado superior (Parálisis congénita del tercer par craneal)
Aponeurótico: inserción defectuosa de la aponeurosis en la superficie anterior de los párpados.
www.qxmedic.com PAG. 9 OFTALMOLOGÍA
Figura 3. Esta es la apariencia típica de un chalazión, que se desarrolla debido a la obstrucción y la posterior inflamación granulomatosa de la glándula de Meibomio.
Figura 5. Ptosis palpebral izquierda
Adquirido
Ptosis aponeurótica
♦ Causa más común de ptosis adquirida
♦ Causada por dehiscencia o estiramiento de la aponeurosis del músculo elevador del párpado superior.
♦ Más frecuente en personas de edad avanzada y en usuarios de lentes de contacto
Miogénico
♦ Miopatía hipotiroidea
♦ Síndromes miotónicos (Distrofia miotónica tipo I) Mecánico
♦ El peso excesivo en el párpado superior (Hemangioma, hematoma, infecciones, tumores del párpado superior) impide la apertura completa del ojo.
♦ Provoca debilidad del músculo elevador del párpado superior.
Neurogénico:
♦ Parálisis del nervio motor ocular común (fibras parasimpáticas)
Neuropatía diabética (pupila normal)
– Aneurisma de la arteria comunicante posterior o hernia uncal (Compresión del núcleo del III par craneal) (pupila midriática)
Isquemia del nervio motor ocular común
♦ Enfermedad neuromuscular (Miastenia gravis, botulismo)
♦ Lesión del nervio simpático: síndrome de Horner
– Causa más común: tumor de Pancoast (carcinoma epidermoide de pulmón) ubicado en ápice de pulmón
Presenta ptosis por debilidad del músculo de Muller (fibras simpáticas)
– Asocia con miosis + anhidrosis + enoftalmos ipsilateral a la lesión

Traumático
Recuerda
Ptosis palpebral + midriasis = compresión del núcleo del III par craneal (aneurisma de comunicante posterior)

Sindrome causado por compromiso del simpático a nivel cervical (Y también ptosis)
ENOFTALMIA MIOSIS ANHIDROSIS
Es un sindorme común en enfermedades neoplásicas del ápice del púlmon
El lado de la cara afectada es homolateral a la lesión
www.qxmedic.com OFTALMOLOGÍA PAG. 10
–
–
–
Figura 6. Síndrome de Claude Bernard Horner
Ectropión
DEFINICIÓN
El párpado se pliega hacia afuera (generalmente el párpado inferior)
ETIOLOGÍA
Ectropión congénito
Síndrome de Down
Microftalmia
Ectropión adquirido
Involucional: debido a la laxitud relacionada con la edad de las placas tarsales
Cicatricial: debido a un traumatismo, inflamación, quemaduras, cirugía, cáncer (carcinoma basocelular es el tumor palpebral maligno más frecuente)
Paralítica: paresia del musculo orbicular del ojo debido a la parálisis del nervio facial (VII par craneal)
Ectropión mecánico: masa o edema conjuntival (quemosis)
DIAGNÓSTICO
Hiperemia conjuntival


Visión borrosa
Fotofobia
Lagoftalmos
Epífora
COMPLICACIONES
Conjuntivitis
Queratoplastia por exposición
Pérdida de visión

www.qxmedic.com PAG. 11 OFTALMOLOGÍA
Figura 7. Ectropión en el parpado inferior
Figura 8. Carcinoma basocelular es el tumor palpebral maligno más frecuente su localización típica es el párpado inferior
02. PATOLOGÍA DE ANEXOS: SISTEMA LAGRIMAL
Dacrioadenitis
DEFINICIÓN:
Inflamación aguda de la glándula lagrimal.
ETIOLOGÍA:
Infección (más común)
♦ Viral: parotiditis, VEB, CMV, herpes zoster
♦ Bacterianas: S. aureus, Streptococcus, Gonoco, Mycobacterium tuberculosis
♦ Hongos: histoplasmosis , blastomicosis
Inflamatorio
Recuerda
La causa más frecuente de canaliculitis es la bacteria actinomices sp.
Recuerda
El síndrome de Mikulicz es una condición inflamatoria, usualmente benigna y crónica, caracterizada por el agrandamiento de las glándulas salivales (parótida) y lagrimal que ocurre como una complicación de otra enfermedad, tal como un linfoma, leucemia, sarcoidosis.
GLÁNDULA PRINCIPAL
CANALÍCULOS
CONDUCTO NASOLACRIMAL
DIAGNÓSTICO:
Dolor / malestar unilateral sobre la glándula lagrimal (párpado superior lateral) Ptosis característica en forma de S¨. Puede haber fiebre y agrandamiento de los ganglios linfáticos preauriculares ipsilaterales.


www.qxmedic.com PAG. 13
Figura 10. La hinchazón y el enrojecimiento debido a la dacrioadenitis aguda son visibles en el área del ojo izquierdo, especialmente en el párpado superior lateral. Se puede ver una ptosis característica en forma de S
Figura 9. Sistema lagrimal, recordar que el conducto nasolagrimal drena en el meato inferior
SACO LAGRIMAL
MEATO INFERIOR
TRATAMIENTO:
La dacrioadenitis viral puede ser autolimitada Antibióticos intravenosos de amplio espectro: en pacientes febriles, presencia de secreción purulenta, cultivos de frotis de ojo positivos.
Dacriocistitis
DEFINICIÓN:
Inflamación aguda del saco lagrimal.

ETIOLOGÍA:
Dacrioestenosis congénita / adquirida → estasis de lágrimas → infección bacteriana secundaria (S. aureus) → inflamación del saco lagrimal.
DIAGNÓSTICO:
Eritema, edema, calor y dolor significativo debajo del canto medial del ojo La presión sobre la hinchazón provoca dolor y secreción purulenta del punto. Epífora Fiebre (puede estar presente)


TRATAMIENTO:
Sintomático: compresas calientes, AINES Antibióticos sistémicos: clindamicina oral, amoxicilina + ácido clavulánico, vancomicina EV pueden usarse empíricamente
Incisión y drenaje si ocurre un absceso del saco lagrimal Cirugía: Dacriocistorrinostomía (tratamiento de la obstrucción)
Dacrioestenosis
Es la obstrucción del conducto nasolagrimal, puede ser de dos tipos
Dacriostenosis congénita
Definición: atresia / obstrucción congénita del conducto nasolagrimal en un lactante Incidencia: hasta el 6% de los nacidos vivos (condición común)
Patogenia: La válvula de Hasner se ve como un pliegue mucoso que obstruye el tercio distal del conducto nasolagrimal
www.qxmedic.com OFTALMOLOGÍA PAG. 14
Figura 11. Dacriocistitis aguda
Glándula lacrimal Conductos lagrimales
Pelicula lagrimógena Válvula de Hasner Cornete inferior
Figura 12. Dacriostenosis congénita (válvula de Hasner)
Diagnóstico:
♦ Epífora dentro de 2- 4 semanas de nacimiento
Tratamiento:
♦ Masaje del saco lagrimal: manejo inicial + importante
♦ Sondaje o intubación del conducto nasolagrimal
♦ Dacriocistorrinostomía como último recurso en casos refractarios o anatomía anormal
Recuerda
Dacrioestenosis congénita es la causa más común de epifora en los bebés. Figura 14. Técnica de masaje del conducto nasolagrimal
(A) El dedo índice se coloca sobre la cara superior del saco nasolagrimal y se aplica una presión moderada hacia abajo.
(B) La presión hacia abajo provoca la ruptura de la obstrucción membranosa en la parte inferior del conducto nasolagrimal.
Dacriostenosis adquirida
Etiología
♦ Enfermedades granulomatosas: sarcoidosis; vasculitis, tuberculosis
♦ Estenosis del punto lagrimal: debido a una conjuntivitis crónica

♦ Estenosis postraumática (fractura / cirugía nasal)


Las características clínicas, el diagnóstico y las complicaciones son similares a las de la dacrioestenosis congénita.
Tratamiento
♦ Manejo del trastorno subyacente

♦ Sonda / intubación del conducto lagrimal: en todos los pacientes
♦ Dacriocistorrinostomía en casos refractarios
www.qxmedic.com PAG. 15 OFTALMOLOGÍA
A. B.
Figura 13. Epifora crónica en un lactante con dacrioestenosis
PATOLOGÍA INFLAMATORIA DE LA ÓRBITA
Celulitis periorbitaria (Preseptal)
DEFINICIÓN
Una infección del párpado y los tejidos blandos periorbitarios sin afectación del contenido orbitario.
Anterior al tabique orbitario
ETIOLOGÍA
Complicación de la infección del tracto respiratorio superior, más comúnmente debido a rinosinusitis bacteriana (Niños: sinusitis etmoidal)
EPIDEMIOLOGÍA
Más común en niños que en adultos
Mucho más común que la celulitis orbitaria
DIAGNÓSTICO
Dolor ocular
Párpado hinchazón y eritema
Con menos frecuencia, quemosis y fiebre
TRATAMIENTO
Para enfermedad leve no sistémica sin fiebre, antibióticos orales (Amoxicilina - ácido clavulánico) y seguimiento ambulatorio cercano.
Celulitis orbitaria (Postseptal)
DEFINICIÓN
Una infección del contenido orbitario, como la grasa y los músculos extraoculares.
Posterior al tabique orbitario
ETIOLOGÍA
Complicación de la infección del tracto respiratorio superior, más comúnmente debido a rinosinusitis bacteriana (Niños: sinusitis etmoidal)
DIAGNÓSTICO
Además de los que se presentan en la celulitis periorbitaria
Proptosis (protrusión hacia adelante del globo ocular)

Oftalmoplejía (el dolor es más severo y restringe los movimientos)
↓ agudeza visual
www.qxmedic.com PAG. 17
03
TRATAMIENTO
El tratamiento antibiótico intravenoso empírico incluye vancomicina + uno de los siguientes: ceftriaxona, cefotaxima, ampicilina-sulbactam, piperacilina-tazobactam. El drenaje quirúrgico está indicado en la formación de abscesos.


COMPLICACIONES
Absceso subperióstico, orbitario o cerebral Trombosis del seno cavernoso (ENAM 2011): cefalea, parálisis de pares craneales (III, IV, V1, V2 y / o VI), edema periorbitario y proptosis de forma bilateral.

www.qxmedic.com OFTALMOLOGÍA PAG. 18
Figura 15. Celulitis orbitaria se complica con trombosis del seno cavernoso (ENAM 2011)
PATOLOGÍA DE LA CONJUNTIVA: CONJUNTIVITIS 04.
Es la causa más frecuente de ojo rojo Consulta oftalmológica más frecuente.
Presenta las siguientes características:
Inyección conjuntival o hiperemia conjuntival (ENAM 2012)
Sensación de ardor, cuerpo extraño o arenilla (ojo rojo indoloro)(ENAM 2012)
Secreción y epífora (lagrimeo)(ENAM 2012)
Quemosis: edema de la conjuntival bulbar Agudeza visual conservada
Recuerda
Ojo rojo indoloro primero pensar en conjuntivitis, diagnóstico diferencial hemorragia subconjuntival (hiposfagma)

Conjuntivitis en adultos
CONJUNTIVITIS BACTERIANA


ETIOLOGÍA:
Recuerda
Síndrome de Reiter uretritis (C trachomatis) + artritis + conjuntivitis.
S. aureus (más común en adultos y niños)
H. influenzae
Gonococo (antecedente ITS: uretritis en varón)
C. trachomatis tipo A – C (conjuntivitis crónica → TRACOMA)
♦ Vía de infección: (directo de humano a humano contacto con los ojos o la nariz) o indirectos (moscas o toallas)
♦ Período de incubación: 5 a 12 días.
DIAGNÓSTICO:
Secreción purulenta profusa (polimorfonucleares)
Generalmente unilateral Formación de pseudomembranas o legañas
Tracoma: Folículos → Pannus corneal → Opacidad corneal (ceguera)
www.qxmedic.com PAG. 19
Figura 16. Hiperemia conjuntival: conjuntivitis aguda
Figura 17. Conjuntivitis bacteriana: secreción purulenta
Recuerda
La conjuntivitis aguda por C. trachomatis produce secreción purulenta y forma folículos, su tratamiento es con doxiciclina.
(ENAM EXTRA 2021)
Recuerda
En la conjuntivitis aguda purulenta, está contraindicado la oclusión ocular
(ENAM 2006)
Recuerda
Tanto los virus como C. trachomatis (bacteria intracelular obligada) forman folículos en la conjuntiva.

(ENAM EXTRA 2021)
Recuerda

Conjuntivitis alérgica es una reacción de hipersensibilidad tipo I (Ig E)
TRATAMIENTO:
Antibióticos tópicos de amplio espectro (polimixina B) Lavado ocular y buena higiene de manos (↓ contagio)
Tracoma → azitromicina VO dosis única
CONJUNTIVITIS VIRAL
ETIOLOGÍA:
Adenovirus (más común) (ENAM EXTRA 2021)
♦ Fiebre faringoconjuntival (serotipo 3 –4 – 7)

♦ Queratoconjuntivitis epidémica (serotipo 8 – 19 – 37)

Virus herpes simple (VHS 1 en niños y VHS 2 en adultos y RN)
DIAGNÓSTICO:
Secreción acuosa o serosa (linfocitos) Generalmente bilateral Formación de folículos
Ganglio preauricular (ENAM EXTRA 2021)
Antecedente: infección respiratoria alta Hemorragias conjuntivales (ENAM EXTRA 2021)
TRATAMIENTO:
Antinflamatorios tópicos Compresas frías y húmedas, lágrimas artificiales Lavado ocular y buena higiene de manos (↓ contagio)
www.qxmedic.com OFTALMOLOGÍA PAG. 20
Figura 19. Conjuntivitis viral: reacción folicular
Figura 18. TRACOMA: cojuntivitis por C. trachomatis, vemos la opacidad corneal (izquierda) y reacción folicular (derecha)
CONJUNTIVITIS ALÉRGICA
ETIOLOGÍA:
Estacional o vernal (polen, ácaros del polvo)
Conjuntivitis papilar gigante (usuarios de lentes de contacto)
Queratoconjuntivitis atópica (asocia a dermatitis atópica)

Queratoconjunvitis flictenular (microbioalergia)
Recuerda
La queratoconjuntivitis flictenular es una reacción de hipersensibilidad tipo IV (retardada) inducida por las proteínas bacterianas (estafilococo, clamidia) considerada una microbioalergia donde el síntoma predominante es el prurito
DIAGNÓSTICO:
Prurito intenso y quemosis (ENAM EXTRA 2020)

Secreción mucosa (eosinófilos) (ENAM EXTRA 2020)
Formación de papilas
TRATAMIENTO:
Antihistamínicos tópicos (olopatadina), estabilizador de mastocitos (ketotifeno) Corticoides en casos severos (papilar gigante)
Papilas gigantes con forma de adoquín en la conjuntiva tarsal del párpado superior del ojo de un paciente que usa lentes de contacto.
Conjuntivitis en recien nacido (Oftalmia neonatal)
CONJUNTIVITIS BACTERIANA: CLAMIDIA
ETIOLOGÍA:
Recuerda
En neonatología el caso clínico típico de lactante con conjuntivitis + neumonitis = infección por Clamidia.
Chlamydia trachomatis tipo D – K (causa cervicitis en ♀) Causa más común de conjuntivitis en RN (conjuntivitis de inclusión)

DIAGNÓSTICO:
Presentación: 5 a 14 días de vida (ENAM 2017)
Secreción mucopurulenta (ENAM 2017)
Formación de folículos
Cultivo en células McCoy: cuerpos de inclusión
Complicación: neumonitis

www.qxmedic.com PAG. 21 OFTALMOLOGÍA
Figura 22. Conjuntivitis papilar gigante
Figura 20. Conjuntivitis alérgica: reacción papilar
Figura 21. Conjuntivitis alérgica: quemosis o edema conjuntival con secreción mucosa
TRATAMIENTO:
Eritromicina 50 mg/kg/día por 14 días
CONJUNTIVITIS BACTERIANA: GONOCOCO

ETIOLOGÍA:
Neisseria gonorrhoeae (causa cervicitis en ♀)


DIAGNÓSTICO:
Presentación: < 3 días de vida (hiperaguda) (ENAM 2004)
Secreción purulenta (+++)(ENAM 2004)
Tinción GRAM: diplococo gram negativo
Complicación: artritis séptica, meningitis, sepsis.

TRATAMIENTO:
Ceftriaxona 25 mg/kg/día dosis única por vía IM
CONJUNTIVITIS VIRAL ETIOLOGÍA

Virus herpes simple (VHS 2)
DIAGNÓSTICO
Presentación: < 14 días de vida
Secreción acuosa
Vesículas perioculares
TRATAMIENTO
Aciclovir
www.qxmedic.com OFTALMOLOGÍA PAG. 22
Figura 23. Conjuntivitis de inclusión por Clamidia: reacción folicular
Figura 24. Cultivo en células McCoy: cuerpos de inclusión
Figura 25. Conjuntivitis por gonococo: hiperaguda e hiperpurulenta
Figura 26. Tinción GRAM: diplococo gram negativo
05. PATOLOGÍAS DE LA CÓRNEA Y ESCLERA



Queratitis
La queratitis es una inflamación de la córnea de forma superficial o profunda (intersticial). Presenta las siguientes características:
Inyección o hiperemia ciliar
Ojo rojo doloroso
Agudeza visual alterada (visión borrosa)
Triada clásica: fotofobia + blefaroespasmo + lagrimeo Usa lámpara hendidura: tinción con fluoresceína
Recuerda
La tríada de Hutchinson es una manifestación cardinal de la sífilis congénita tardía = queratitis intersticial + hipoacusia neurosensorial + dientes en tonel
QUERATITIS BACTERIANA
GENERALIDADES
Forma más común de queratitis (+ 90%) ↑ Riesgo el uso de lentes de contacto Complicación de una conjuntivitis aguda
ETIOLOGÍA:
S aureus (+ común)
Pseudomonas aeruginosa (en usuarios de lentes de contacto)
Sífilis, tuberculosis → queratitis intersticial (+ profunda y compromete el estroma)
www.qxmedic.com PAG. 23
Figura 28. La membrana de Descemet forma parte de las capas de córnea, es la zona donde se deposita cobre en la enfermedad de Wilson produciendo el anillo de Kayser – Fleischer en la córnea
ESCLERA CÓRNEA EPITELIO BOWMAN ESTROMA DESCEMET ENDOTELIO
Figura 27. Las capas externas del globo ocular son la córnea que cubre la 1/6 anterior del ojo y la esclera que cubre los 5/6 posteriores restantes
Figura 29. Hiperemia ciliar
DIAGNÓSTICO:
Úlcera blanca regular (redonda)
Pus en cámara anterior (hipopion)



TRATAMIENTO:
Antibióticos tópicos de amplio espectro (Ciprofloxacina, cefazolina, gentamicina)
Recuerda
La reacción cruzada por la infección herpética produce la queratitis disciforme cuyo tratamiento es con corticoides.
Los glucocorticoides no deben usarse en el tratamiento de una infección activa por herpes.
QUERATITIS VIRAL
ETIOLOGÍA:
Virus herpes simple (VHS 1 > VHS 2)
DIAGNÓSTICO:
Ulcera dendrítica
Ulcera geográfica (se complica por el uso de corticoides)
Prueba de reacción en cadena de la polimerasa (PCR)
TRATAMIENTO:
Aciclovir tópico → vía oral

QUERATITIS MICÓTICA
GENERALIDADES
Antecedente de trauma vegetal (Madera, espina, ramas)(ENAM 2005)
El uso de glucocorticoides y antibióticos aumenta el riesgo de infección por hongos
ETIOLOGÍA:
Aspergillus sp (causa más común en nuestro medio)
Fusarium (+ común en USA)
Candida sp
DIAGNÓSTICO:
Ulcera aplumillada (blanca irregular) (ENAM 2005)
TRATAMIENTO:
Nistatina tópica
Anfotericina B sistémica
www.qxmedic.com OFTALMOLOGÍA PAG. 24
Figura 30. Queratitis bacteriana por estafilococo sp: Úlcera blanca regular (redonda)
Figura 31. Queratitis herpética: úlcera dendrítica
Figura 32. Queratitis micótica: Ulcera aplumillada (blanca irregular)
QUERATITIS PARASITARIA
ETIOLOGÍA:
Acanthamoeba sp (ameba de vida libre)
↑ Riesgo el uso de lentes de contacto
DIAGNÓSTICO:
Ulcera en forma de anillo (ENAM 2016)
Curso progresivo durante varias semanas a pesar de un intento de tratamiento con antibióticos
TRATAMIENTO:
Antiséptico tópico (por ejemplo, clorhexidina) con propamidina
Epiescleritis
GENERALIDADES
Inflamación de las capas superficiales de la esclera
Edad media: + 45 años, ♀ > ♂
ETIOLOGÍA:
Más comúnmente idiopática
Asociado con enfermedad sistémica subyacente (más comúnmente artritis reumatoide)
Reacción a medicamentos (p. Ej., Bisfosfonatos)
CLASIFICACIÓN
Difusa: subtipo más común
Nodular / focal: por lo general ocurre en los pacientes con enfermedad sistémica subyacente.
DIAGNÓSTICO:
Inicio agudo de síntomas
Unilateral en hasta el 70% de los casos Dolor / irritación ocular leve y lagrimeo
Enrojecimiento de los ojos (ojo rojo)


Desaparece (blanquea) con gotas oftálmicas vasoconstrictoras (fenilefrina)
La agudeza visual esta normal
TRATAMIENTO:
Tratamiento sintomático (p. Ej., Compresas frías, lubricación ocular)
En casos persistentes o graves: AINE y / o esteroides tópicos

www.qxmedic.com PAG. 25 OFTALMOLOGÍA
Figura 33. Queratitis parasitaria: Ulcera en forma de anillo
Figura 34. Epiescleritis en una mujer de 40 años
Escleritis
Recuerda
Para evaluar la presencia de una enfermedad sistémica subyacente: FR, ANA y ANCA.
GENERALIDADES
Inflamación transmural de la esclera
Edad media: 40 a 60 años, ♀ >
ETIOLOGÍA:
Hasta en 60% de los pacientes, la escleritis se asocia con una enfermedad sistémica subyacente (más comúnmente artritis reumatoide, pero también LES, poliangeítis, polimiositis y gota).
CLASIFICACIÓN
Escleritis anterior
♦ No necrosante (nodular o difuso)
♦ Necrosante
– Con inflamación (dolor intenso y enrojecimiento de los ojos)
Sin inflamación (indolora) → escleromalacia perforante (grave)
Escleritis posterior
DIAGNÓSTICO:
Inicio subagudo de síntomas
Bilateral hasta en el 50% de los casos
Dolor ocular severo, que se ve agravado por el movimiento ocular y palpación
Enrojecimiento de los ojos (ojo rojo)
Fotofobia y / o pérdida de visión.
No desaparece (blanquea) con gotas oftálmicas vasoconstrictoras (fenilefrina)
Recuerda
La complicación ocular más frecuente en paciente con artritis reumatoide es la xeroftalmia (ojo seco), la más específica es la escleritis y la más grave es la queratomalacia perforante

TRATAMIENTO:
AINE: tratamiento de primera línea en casos leves a moderados
Glucocorticoides sistémicos: en escleritis posterior o necrotizante; pacientes que no responden a los AINE
Terapia inmunosupresora sistémica (p. Ej., Azatioprina, metotrexato): en pacientes que no responden a los esteroides

www.qxmedic.com OFTALMOLOGÍA PAG. 26
♂
Figura 35. Escleritis en una mujer con artritis reumatoide
–
06. PATOLOGÍA DE LA ÚVEA
Inflamación de la capa media del globo ocular, presenta la siguiente clasificación anatómica:
Uveitis anterior (Iridociclitis)
ETIOLOGÍA
La mayoría de los casos son idiopáticos (hipersensibilidad tipo III)
Asocia a HLA B27
Causas secundarias:
♦ Espondilitis anquilosante (Causa + común en jóvenes)

Recuerda
Joven con dolor de espalda, test de Schober +, sacroileitis con uveítis anterior, HLA B27 pensar en espondilitis anquilosante
Recuerda
Ojo rojo doloroso con miosis + efecto de Tyndall positivo = uveítis anterior.
DIAGNÓSTICO
Dolor periocular sordo y progresivo
Hiperemia ocular (ojo rojo) + miosis

Fotofobia
Disminución de la agudeza visual (visión borrosa).
Aumento del lagrimeo (epífora)
Hipopion (pus en cámara anterior)
Efecto de Tyndall positivo (Proteína en el humor acuoso)
♦ Artritis reumatoide juvenil idiopática (Causa + común en adolescentes)
♦ Artritis reumatoide
♦ Enfermedad inflamatoria intestinal
♦ LES
Las causas infecciosas incluyen HSV y VZV.
36. Espondilitis anquilosante se asocia con sacroileitis, ↓ amplexación lumbosacro, HLA B27, es la causa secundaria más frecuente de uveítis anterior en jóvenes
www.qxmedic.com PAG. 27
Figura
Figura 37. Uveítis anterior, nótese la miosis y la presencia de hipopion
COMPLICACIONES
Catarata
Glaucoma secundario

Desprendimiento de retina
Edema de mácula
Uveitis intermedia (Parsplanitis)

ETIOLOGÍA
Idiopáticas (más frecuente)
Esclerosis múltiple

Sarcoidosis
DIAGNÓSTICO
TRATAMIENTO
Corticoides tópicos
Ciclopléjicos (atropina, escopolamina)
El sello distintivo de la uveítis intermedia es la inflamación del vítreo. Disminución de agudeza visual indolora Fondo de ojo: imagen en copos de nieve (condensados vítreos)
TRATAMIENTO
Corticoides
www.qxmedic.com OFTALMOLOGÍA PAG. 28
Figura 38. Esclerosis múltiple es la desmielinización del sistema nervioso a nivel central
Figura 39. Uveítis intermedia: imagen en copos de nieve
Uveitis posterior (Coreorretinitis)


ETIOLOGÍA
A menudo causado por una infección:
♦ Toxoplasmosis (Causa + común en inmunocompetentes)

♦ Virus (citomegalovirus → causa + común en inmunosuprimidos, infectados VIH)
♦ Sífilis
♦ Tuberculosis
♦ Histoplasmosis
♦ Enfermedad por arañazo de gato (unilateral)
♦ enfermedad de Lyme

Las causas no infecciosas incluyen enfermedad de Behçet (panuveitis recurrente remitente), LES, EII, poliangeítis y poliarteritis nodosa.
DIAGNÓSTICO
Alteraciones visuales indoloras. Disminución de la agudeza visual (visión borrosa).
Fondo de ojo
♦ Lesiones atróficas amarillentas (toxoplasma)
♦ Lesiones necróticas hemorrágicas (citomegalovirus)
TRATAMIENTO
Sulfadiazina + pirimetamina → toxoplasma
Ganciclovir o foscarnet → citomegalovirus
VHS → aciclvoir
www.qxmedic.com PAG. 29 OFTALMOLOGÍA
Figura 41. Coreorretinitis por toxoplasma: Lesiones atróficas amarillentas
Figura 42. Coreorretinitis por citomegalovirus: Lesiones necróticas hemorrágicas
Figura 40. Toxoplasmosis es la causa más frecuente de coreorretinitis
07. GLAUCOMA



El glaucoma es un grupo de enfermedades oculares asociadas con la destrucción aguda o crónica del nervio óptico con o sin aumento concomitante de la presión intraocular (PIO).
Glaucoma crónico (ángulo abierto)
GENERALIDADES
Pérdida progresiva generalmente bilateral de las fibras del nervio óptico con ángulo iridocorneal abierto > 30 grados (a menudo con aumento de la PIO)
Principal causa de ceguera irreversible en menores de 65 años.
FACTORES DE RIESGO
Edad > 40 años
Etnia europea o africana
Diabetes mellitus, HTA
Predisposición familiar
Miopía alta (magna)
Corticoides
FISIOPATOLOGÍA

Obstrucción funcional del trabeculum → drenaje del humor acuoso reducido →↑gradual en la PIO → compresión vascular → isquemia del nervio óptico → deterioro visual progresivo.
DIAGNÓSTICO
Inicialmente a menudo asintomático
Pérdida del campo visual generalmente bilateral y progresiva (de periférico a central) Visión tunelizada
Tonometría: > 20 mmHg (solo en un 40% de los pacientes)
Fondo de ojo: ↑ excavación del disco óptico > 30%
Campimetría: Escotoma paracentral
www.qxmedic.com PAG. 31
IRIS
Figura 43. Bloqueo funcional del trabeculum en glaucoma crónico (ángulo abierto)
Figura 44. Visión tunelizada en glaucoma crónico
Figura 45. Aumento de la excavación del disco óptico en glaucoma crónico
L MS2 = 24,8 MS3 = 14,0 MS1 = 23,5 MS4 = 23,2 R
Figura 46. Escotoma paracentral en glaucoma crónico
TRATAMIENTO
Objetivo de la terapia (PIO objetivo): ≥ 25% de disminución de la PIO antes del tratamiento Análogos tópicos de prostaglandinas (PGF2α+ potentes): ↑ excreción humor acuoso
♦ Latanoprost
♦ Travoprost
Beta Bloqueadores: ↓ síntesis del humor acuoso
♦ Timolol (ENAM 2016)
♦ Betaxolol
Agonistas alfa-2: ↓ síntesis del humor acuoso (↓ AMPc)
♦ Brimonidina
♦ Apraclonidina
Trabeculoplastia con láser argón: ablación térmica de las células de la malla trabecular y mejorar el flujo de salida acuoso.
Trabeculectomía quirúrgica: consiste en la creación de un túnel (mediante la escisión de la malla trabecular)
PREVENCIÓN
La detección de glaucoma se recomienda en los siguientes grupos de pacientes:
Historia personal de diabetes mellitus
Antecedentes familiares de glaucoma

Afroamericanos > 50 años de edad
Hispanoamericanos > 65 años de edad
Glaucoma agudo (Ángulo cerrado)
GENERALIDADES
Aumento repentino y brusco de la presión intraocular causado por una obstrucción del flujo de salida del humor acuoso, con ángulo iridocorneal cerrado < 30 grados y asociado con neuropatía óptica y defectos del campo visual.
El glaucoma agudo de ángulo cerrado es una emergencia médica, ya que puede causar pérdida permanente de la visión.
FACTORES DE RIESGO
Hipermetropía (ENAM 2017)
Edad avanzada
Sexo femenino
Etnia asiática
Anticolinérgicos (Atropina)
FISIOPATOLOGÍA
Bloqueo anatómico de la red trabecular → ↓ drenaje del humor acuoso del ojo → ↑ PIO

www.qxmedic.com OFTALMOLOGÍA PAG. 32
IRIS
Figura 47. Bloqueo anatómico del trabeculum en glaucoma agudo (ángulo cerrado)
DIAGNÓSTICO
Inicio repentino de síntomas y de afectación unilateral
Ojo rojo muy doloroso (duro a la palpación)
(ENAM 2017, 2014)
Pupila medianamente dilatada (midriasis: 4-6 mm), irregular y arreactiva.
(ENAM 2017)
Cefalea, vómitos, náuseas.
Recuerda
Ojo rojo muy doloroso con midriasis arreactiva = Glaucoma agudo.
(ENAM 2017, ENAM 2014)
TRATAMIENTO
Visión borrosa y halos visibles alrededor de la luz.
Tonometría: > 30 mmHg (40 – 90 mmHg)
Gonioscopía: Prueba de oro para evaluar el ángulo iridocorneal (cerrado)
Complicaciones: pérdida rápida y permanente de la visión debido a isquemia y atrofia del nervio óptico
Figura 48. Glaucoma agudo o de ángulo cerrado, nótese la midriasis arreactiva
El glaucoma agudo de ángulo cerrado es una emergencia y debe tratarse inicialmente con medicamentos que reducen la PIO que tienen un inicio de acción rápido.
♦ Diuréticos:
– Acetazolamida (inhibidor de anhidrasa carbónica) (Via oral)(ENAM 2006)
– Manitol (diurético osmótico) EV
Parasimpaticomimético directo: pilocarpina (agonista muscarínico M3)
Terapia intervencionista urgente

♦ Paracentesis de cámara anterior (medida temporal)
♦ Iridotomía periférica con láser YAG
Glaucoma congénito
GENERALIDADES
Recuerda
El tumor de Wilms tiene mayor incidencia en los niños que presentan ciertas anomalías o síndromes al nacer, entre ellos: Aniridia.
Bilateral en + 75% de los casos
La mayoría de los casos se diagnostican durante el primer año de vida.
ETIOLOGÍA
Glaucoma congénito primario: ocurrencia esporádica o herencia autosómica recesiva
♦ Membrana de Barkan → ↓ drenaje del humor acuoso → ↑ PIO
Glaucoma congénito secundario: debido a traumatismo, infección, tumor, otras anomalías oculares congénitas (Aniridia) o glaucoma asociado con anomalías congénitas sistémicas (Facomatosis, síndrome de Down)
♦ Malformación de la red trabecular e iris o córnea → ↓ drenaje del humor acuoso → ↑ PIO

www.qxmedic.com PAG. 33 OFTALMOLOGÍA
DIAGNÓSTICO
Buftalmos (globo ocular agrandado por ↑ PIO)(ENAM EXTRA 2020) Opacidad de la córnea (ENAM EXTRA 2020)

Fotofobia, epífora
Estrías de Haab (ruptura de membrana de Descemet)
Paquimetría: Diámetro corneal aumentado (> 12 mm)


Pruebas genéticas: Gen CYP1B1
TRATAMIENTO Cirugía
Goniotomía: si la córnea esta transparente Trabeculoplastía: si la córnea esta opaca (ENAM EXTRA 2020)
Glaucoma secundarios
Neovascular: diabéticos
Inflamatorio: uveítis anterior Facolítico: catarata
www.qxmedic.com OFTALMOLOGÍA PAG. 34
Figura 49. Buftalmos en glaucoma congénito Figura 50. Estrías de Haab en glaucoma congénito
08. PATOLOGÍA DE LA RETINA
Retinopatía diabética
EPIDEMIOLOGÍA
Complicación crónica de la diabetes (15 años de enfermedad)
90% de los pacientes diabéticos tipo 1
25% de los pacientes diabéticos tipo 2
La segunda causa más común de ceguera irreversible en < 65 años (después del glaucoma)
Enfermedad vascular más común de la retina
PATOGENIA
Glicosilación de proteínas
↑ vía del sorbitol
Oclusión microvascular: lesión endotelial, ↑ agregación plaquetaria, ↑ viscosidad
Aumento de la permeabilidad vascular (edema, exudados), engrosamiento de la membrana basal de capilares.
Neovasos: inducido por VEGF producido por el tejido retiniano hipóxico
DIAGNÓSTICO:
Asintomático hasta etapas muy tardías de la enfermedad.
Disminución de la agudeza visual → ceguera
La evaluación oftalmoscópica se recomienda:
DM1: A los 10 años de edad o durante los 5 años después del diagnóstico
DM2: Al momento del diagnóstico
Diabetes gestacional: Durante el primer trimestre
Primera lesión en fondo ojo: micro aneurismas
Lesiones vasculares: anomalías microvasculares intraretinianas (AMIR), hemorragia intraretinianas, exudados duros edema de retina y manchas algodonosas
Lesiones severas: neovasos, hemorragia vítrea, desprendimiento de retina por tracción.
CLASIFICACIÓN:
Grado Hallazgos en fondo de ojo
RDNP leve Micro aneurismas
RDNP moderada < 20 hemorragias intraretinianas, exudados duros, exudados algodonosos (microinfartos de fibras nerviosas) y arrosariamiento venoso.
RDNP severa Uno de los siguientes hallazgos: 4: Hemorragias
intraretinianas 2: Arrosariamiento venoso 1: Anomalías microvasculares intraretinianas
RDNP muy severa Al menos 2 de los hallazgos anteriores
RD proliferativa Neovascularización y/o hemorragia vítrea
RDNP: retinopatía diabética no proliferativa
www.qxmedic.com PAG. 35
Tabla 1. Clasificación de la retinopatía diabética
Se pueden observar exudados duros (áreas amarillas bien delimitadas) y pequeñas hemorragias intraretinianas (manchas rojas) en toda la retina
COMPLICACIONES:
Hemorragia vítrea: principal causa de ↓AV de forma aguda
Desprendimiento de retina: principal causa de ↓AV de forma subaguda
Edema de macula: principal causa de ↓AV de forma crónica (en general es la causa más frecuente de visión borrosa en el paciente diabético)
Recuerda

La principal causa de pérdida de visión en paciente diabético es el edema de la macula
TRATAMIENTO
Retinopatía no proliferativa
Tratamiento con láser: fotocoagulación focal. Inyección intravítrea de inhibidor del factor de crecimiento endotelial vascular (Anti VEGF= ranibuzumab)
Retinopatía proliferativa

Tratamiento con láser: fotocoagulación panretiniana Vitrectomía en caso de desprendimiento de retina por tracción y hemorragia vítrea


Retinopatía hipertensiva
Cambios arterioscleróticos relacionados con la hipertensión de los vasos retinianos. Hay una vasoconstricción reactiva inicial (vasoespasmo) y, con el tiempo, la ruptura de la barrera hemato-retiniana con hemorragia y exudación subsiguientes.
Tratamiento: el control de la presión arterial sistémica
www.qxmedic.com OFTALMOLOGÍA PAG. 36
Figura 51. Retinopatía diabética no proliferativa
Figura 52. Retinopatía diabética proliferativa Hay aumento de la vascularización alrededor del disco óptico
Figura 53. Edema de macula identificada con tomografía de coherencia óptica, principal causa de ceguera en paciente diabético
Estadio I
Estadio II
Estadio III
CLASIFICACIÓN DE KEITH- WAGENER



Estrechamiento de las arterias. Relación arterio- venosa 1/2. (supervivencia del 71% a los diez años)
Marcada esclerosis de arteriolas, exageración del reflejo de la luz, cruces arterio – venosos y estrechamientos (signo de Salus y Gunn) (51% de supervivencia)
Edema retiniano, exudados y hemorragias (Supervivencia del 35%)

Estadio IV Edema de papila y atrofia óptica (21% la supervivencia)
Tabla
A. Cruce normal arterio venoso en la retina
B. Signo de Gunn (aplastamiento)
C. Signo de Salus (cambio de dirección)

A. Reflejo luminoso normal de la arteria de la retina (< 30%)
B. Hilo de cobre: reflejo luminoso es del 50%
C. Hilo de plata: reflejo luminoso es del 100%
Recuerda

El grado I y II de retinopatía se ve en los cuadros crónicos de la HTA, en cambio el grado III y IV son agudos y forman parte de la llamada hipertensión maligna (emergencia hipertensiva)
A. Grado I: vasoconstricción de las arterias de la retina
B. Grado II: cruce arterio-venosos, hilos de cobre y plata
C. Grado III: exudados y hemorragias
D. Grado IV: edema de papila
www.qxmedic.com PAG. 37 OFTALMOLOGÍA
2. Clasificación de KEITH- WAGENER
B. C.
A.
A.
B. C.
A.
B. C. D.
Oclusión de la arteria central de la retina
EPIDEMIOLOGÍA
Edad de inicio: > 60 años
Sexo: ♂ > ♀
La oclusión de la arteria retiniana es una emergencia oftalmológica

ETIOLOGÍA:
Embolia
Liberación de émbolos trombóticos como resultado de la aterosclerosis de la arteria carótida (más común)
Émbolo de la aurícula izquierda (fibrilación auricular)
DIAGNÓSTICO
Pérdida de visión repentina e indolora en un ojo
Puede haber antecedentes de amaurosis fugaz.
Defecto pupilar aferente (pupila de Marcus Gunn)
Fondo de ojo:
♦ Decoloración de color blanco grisáceo (turbio) de toda la retina
♦ Mancha Rojo cereza
♦ Estrechamiento de todos los vasos retiniano
Solicitar: Eco Doppler carotideo → EKG
TRATAMIENTO
Figura 54. Oclusión aguda de la arteria central de la retina
Son visibles las arterias retinianas estrechas y una retina pálida. La fóvea central aparece la mancha rojo cereza
El tratamiento debe iniciarse tan pronto como sea posible, ya que se produce daño en la retina permanente dentro de 1,5 horas de oclusión de la arteria central de la retina.
Masaje de globo ocular
Terapia con carbogen: inhalar una mezcla de 5% de CO 2 y 95% de O 2
Disminuir la presión intraocular con medicamentos y / o terapia quirúrgica (por ejemplo, paracentesis de la cámara anterior)

Hemodilución
Vasodilatadores (p. Ej., Bloqueadores de los canales de calcio, nitroglicerina sublingual)
Tratamiento con dosis altas de glucocorticoides si se sospecha arteritis temporal Fibrinólisis
PRONÓSTICO
Oclusión de la arteria central de la retina: pérdida grave de la visión
www.qxmedic.com OFTALMOLOGÍA PAG. 38
Oclusión de la vena central de la retina
EPIDEMIOLOGÍA
Edad de inicio: > 80 años
Sexo: ♂ = ♀
La oclusión de la vena retiniana es mucho más común que la oclusión de la arteria retiniana. La oclusión de la vena retiniana es la segunda enfermedad vascular más común de la retina (después de la retinopatía diabética).
ETIOLOGÍA: Trombosis
Por lo general, como resultado de la aterosclerosis en pacientes con hipertensión arterial, diabetes mellitus.

Estados protrombóticos: Policitemia vera, uso de anticonceptivos orales
DIAGNÓSTICO
Pérdida de visión subaguda indolora (forma no isquémica)
Pérdida repentina y grave de la visión en el ojo afectado (forma isquémica)
Fondo de ojo:
♦ Hemorragia en llamas (neovasos retinovítreo: capas fibras nerviosas)
♦ Venas tortuosas.
TRATAMIENTO
La forma isquémica debe tratarse con:
Fotocoagulación panretiniana
La hemorragia en forma de llama es visible en los cuatro cuadrantes retinianos
Si hay edema macular: inyección intravítrea de inhibidores de VEGF y / o corticoides (triamcinolona)

PRONÓSTICO
Regla de los tercios: la agudeza visual mejora en un tercio de los casos, permanece igual en otro tercio y empeora en el tercio restante.
El pronóstico es especialmente malo en el caso de OVCR isquémica.
Degeneración macular asociado con la edad
EPIDEMIOLOGÍA
Principal causa de ceguera en personas > 65 años en los países desarrollados.
Edad de inicio: generalmente > 55 años
Sexo: ♀ > ♂
www.qxmedic.com PAG. 39 OFTALMOLOGÍA
Figura 55. Oclusión de la vena central de la retina
ETIOLOGÍA
Multifactorial: Envejecimiento (edad) Factores de riesgo Antecedentes familiares y predisposición genética.

FISIOPATOLOGÍA
Enfermedad cardiovascular Tabaquismo
Obesidad
Se caracteriza por cambios degenerativos progresivos en la retina central (mácula) → discapacidad visual.

CLASIFICACIÓN
Forma seca (90%)
También conocida como no exudativa o atrófica
DIAGNÓSTICO
Metamorfopsias (distorsión de línea) Discromatopsias
Forma seca:
♦ Deterioro visual lento y progresivo (generalmente durante décadas)
♦ FO: DRUSA (retinol)
Forma húmeda (10%)
También conocida como exudativa o neovascular
Forma húmeda:
♦ Pérdida brusca de visión
♦ FO: neovasos coroide – retina
♦ Angiografía de fluorescencia: neovascularización y exudación en la región macular


REJILLA DE AMSLER: detección de metamorfopsias y escotomas
a. Los ojos de una persona sana perciben una cuadrícula de líneas rectas
b. Si hay degeneración macular avanzada las líneas aparecen distorsionadas u onduladas (metamorfopsia).
c. También puede ocurrir un escotoma central
Las drusas son depósitos localizados de material rico en lípidos (fosfolípidos, grasas neutras) ubicados debajo del epitelio pigmentario.
Figura
relacionada con la edad. Gran hemorragia subretiniana (parcialmente intraretinianas) en la región macular. Este hallazgo ocurre principalmente en presencia de neovascularización coroideapigmentario.
www.qxmedic.com OFTALMOLOGÍA PAG. 40
a.
b.
c.
Figura 56. Rejilla de Amsler
Figura 57. Degeneración macular seca relacionada con la edad
58. Degeneración macular húmeda
TRATAMIENTO
El objetivo del tratamiento es retrasar o prevenir la progresión de la enfermedad. Tratamiento de apoyo
Educación del paciente
Evite los factores de riesgo (Tabaco)
Mejorar la dieta (es decir, rica en verduras y pescado)
Terapia con antioxidantes: vitaminas A, C y E, beta caroteno, zinc. Tratamiento de la DMAE húmeda
Primera línea: inyección intraocular de inhibidores de VEGF (ranibizumab, bevacizumab)
Segunda línea: Coagulación con láser: coagulación térmica directa de la neovascularización o terapia fotodinámica.
Desprendimiento de retina
DEFINICIÓN
Se refiere al desprendimiento de la capa interna de la retina (retina neurosensorial) del epitelio pigmentario de la retina.
CLASIFICACIÓN
REGMATÓGENO
Tipo más común
Desgarros o agujeros de retina
TRACCIONAL
Formación de bandas o neovasos vitreo retinianas
EXUDATIVA
Acumulación de líquido subretiniana sin desgarros retinianos
Crecimiento tumoral
FACTORES DE RIESGO
REGMATÓGENO
Roturas de retina periférica, comúnmente debido a:
♦ Miopía patológica (principal factor)
♦ Trauma
TRACCIONAL
Retinopatía diabética proliferativa
Retinopatía del prematuro
Retinopatía de células falciformes
EXUDATIVA
Retinoblastoma, melanoma de coroides
Hipertensión arterial
Cirugía intraocular previa
Antecedentes familiares

Retinitis por CMV

Oclusión de la vena central de la retina
Trauma ocular penetrante
Poliarteritis nodosa
www.qxmedic.com PAG. 41 OFTALMOLOGÍA
Figura 59. Separación de las 9 capas internas del epitelio pigmentario subyacente.
DIAGNÓSTICO
Miodesospsias (imagen de “moscas volando”)
Destellos de luz (fotopsias) (ENAM 2011)
Escotoma (defecto del campo visual): Posible cortina o sombra ascendente normalmente unilateral
Pérdida de visión repentina en el ojo afectado postrauma
Defecto pupilar aferente (pupila de Marcus Gunn)
Presión intraocular baja

TRATAMIENTO
El desprendimiento de retina es una condición de emergencia que requiere una intervención quirúrgica inmediata (excepto exudativo).
Desprendimiento de retina regmatógena: Para agujeros de retina / desgarros de retina con poco o ningún desprendimiento de retina (profilaxis contra el desprendimiento de retina): fotocoagulación con láser o criorretinopexia en las inmediaciones del defecto de retina.
Desprendimiento de retina por tracción: vitrectomía seguida de taponamiento interno y fotocoagulación con láser / criorretinopexia.


Desprendimiento de retina exudativo (seroso): reabsorción espontánea de líquido; no se requiere tratamiento

www.qxmedic.com OFTALMOLOGÍA PAG. 42
B. Desprendimiento de retina traccional
C. Desprendimiento de retina exudativo o seroso
A. Desprendimiento de retina regmatógena
Trastornos del campo visual
La vía visual transmite señales desde la retina a la corteza visual. Está formado por la retina, el nervio óptico, el quiasma óptico, el tracto óptico, el núcleo geniculado lateral, las radiaciones ópticas y la corteza visual.
LESIÓN DE LA VÍA PREQUIASMÁTICA
Afecta principalmente al nervio óptico Y/o retina
Defectos del campo visual: Anopsia monocular ipsilateral
Producido por:
♦ Neuritis óptica (esclerosis múltiple, etambutol)
♦ Atrofia óptica
♦ Oclusión de vasos retinianos

♦ Neuropatía óptica isquémica anterior
♦ Papiledema
LESIÓN DEL QUIASMA ÓPTICO
Defectos del campo visual: hemianopsia heterónima bitemporal (visión tunelizada)(ENAM 2016)
Producido por:
♦ Adenoma pituitario (prolactinoma): lesión medial → fibras nasales → afecta los campos temporales
♦ Craneofaringioma
♦ Aneurisma de la arteria carótida interna: lesión lateral → fibras temporales → afecta los campos nasales
♦ Meningioma
LESIÓN DE LA VÍA RETROQUIASMÁTICA
Daño en la región del tracto óptico, núcleo geniculado lateral, radiación óptica o corteza visual.
Defectos del campo visual: más comúnmente hemianopsia homónima y cuadrantanopsia homónima contralateral
Producido por:
♦ Accidente cerebro vascular (arteria cerebral posterior)
♦ Tumores
♦ Trauma
♦ Aneurisma de la comunicante posterior
♦ Meningitis
REGIÓN PREQUIASMÁTICA ANOPSIA MONO-OCULAR IPSLATERAL
QUIASMA ÓPTICO (ENAM 2016)
REGIÓN RETROQUIASMÁTICA
HEMIANOPSIA HETERÓNIMA BITEMPORAL (ENAM 2016)
HEMIANOPSIA HOMONIMA CONTRALATERAL
www.qxmedic.com PAG. 43 NEUROFTALMOLOGÍA
09.
Figura 60. Defectos del campo visual según la región afectada de la vía óptica
Neuritis óptica


DEFINICIÓN:
Inflamación del nervio óptico
CLASIFICACIÓN:
Anterior o Papilitis: Más frecuente en infancia
Posterior o retrobulbar: Más frecuente en adulto (mujer 20 a 45 años)
ETIOLOGÍA
Causa más común: esclerosis múltiple
Infecciones: tuberculosis, sífilis, enfermedad de Lyme, infecciones virales.
Tóxico: etambutol, intoxicación por metanol
Vasculitis: arteritis de la temporal (forma arterítica)
Isquémica: HTA, DM, dislipidemia (forma no arterítica)
DIAGNÓSTICO
Pérdida repentina de la visión
Defectos del campo visual (Escotoma central)
Dolor por los movimientos oculares
Defecto pupilar aferente (pupila de Marcus Gunn)
Neuritis anterior: papila mal definida, hiperemia, hemorragia en el borde de la papila
Neuritis retrobulbar: hallazgo oftalmoscópico normal
Examinación neurológica (forma retrobulbar)

TRATAMIENTO
Tratamiento de dosis altas con glucocorticoides
Tratamiento correspondiente en caso de esclerosis múltiple
www.qxmedic.com OFTALMOLOGÍA PAG. 44
Figura 61. Neuritis óptica anterior: edema de papila (papilitis)
Figura 62. Neuritis óptica posterior: fondo de ojo normal
10. LESIONES OCULARES TRAUMÁTICAS
Trauma ocular cerrado


Lesión del globo ocular que ocurre en ausencia de una laceración o ruptura de la pared ocular.
Características clínicas:
Abrasión conjuntival y corneal (sensación de cuerpo extraño en el ojo)


Equimosis
Hemorragia subconjuntival (hiposfagma), vítrea o retiniana
Laceración conjuntival o de espesor parcial de la córnea o la esclerótica
Edema de Berlín (conmoción de la retina)
Hifema: sangre en la cámara anterior(ENAM 2004)
♦ Hifema parcial: urgencia
♦ Hifema total: emergencia (cirugía)
Recuerda
Frente a un cuerpo extraño no intraocular se brinda anestesia tópica y extracción del mismo (ENAM EXTRA 2021)


www.qxmedic.com PAG. 45
Figura 63. Hemorragia subconjuntival (hiposfagma)
I < 33 % II 33 - 50 % III > 50 % IV 100 %
Figura 64. Hifema: sangre en la cámara anterior
Figura 65. Grados de hifema
Complicaciones:
Desprendimiento de retina: ↓agudeza visual en telón de cortina

Hemorragia vítrea: ↓agudeza visual súbita Glaucoma





Catarata traumática (roseta)
Trauma ocular abierto
Perforación o laceración de espesor total del globo ocular
Las lesiones penetrantes solo tienen un agujero de entrada.
Las lesiones perforantes tienen dos agüeros uno de entrada y otro de salida.
Características clínicas:
Deformidad macroscópica del ojo (rotura ocular con pérdida de volumen de líquido)
Úvea prolapsada (laceración de espesor total) o salida de humor vitreo
Atalamia: desaparición de la cámara anterior Pupila en forma de lagrima o puntiaguda (ENAM EXTRA 2021)
Tinción con fluoresceína: Signo de Seidel Síndrome compartimental orbitario
♦ Defecto pupilar aferente y alteración de la agudeza visual.
♦ Equimosis y proptosis
♦ Parpados tensos
www.qxmedic.com OFTALMOLOGÍA PAG. 46
Figura 67. Atalamia: desaparición de la cámara anterior Figura 68. Pupila en forma de lagrima (ENAM EXTRA 2021)
Figura 69. Úvea prolapsada (laceración de espesor total) Figura 70. Síndrome compartimental orbitario
Figura 66. Trauma ocular abierto: cuerpo extraño intraocular
Recuerda
Si el cuerpo extraño intraocular es metálico esta contraindicado la evaluación por resonancia magnética. (ENAM EXTRA 2021)
En un trauma ocular abierto se brinda protección ocular y derivar al especialista (ENAM EXTRA 2021)
Fractura de órbita
PISO DE ÓRBITA GENERALIDADES
Es la zona más débil y por tanto el más común
Traumatismo contuso de alta velocidad en el globo ocular (Por un puñetazo, una pelota de tenis)
DIAGNÓSTICO
Dolor, edema y / o equimosis peri orbitarios unilaterales
Enoftalmos o proptosis
(ENAM EXTRA 2021)
Tratamiento

Estabilización y reanimación urgentes (Evaluar y tratar las lesiones que amenazan la vida)
Reposo en cama con la cabecera elevada a 30 grados
No manipulación del globo ocular, no retirar cuerpo extraño, no colocar agentes tópicos
Analgesia (Morfina), antieméticos (Ondansetrón) y vacuna o refuerzo contra el tétanos.
Terapia antibiótica sistémica (ceftazidima + vancomicina)
Consulta oftalmológica urgente para reparación quirúrgica (< 24 horas)(ENAM EXTRA 2021)

Borde orbital " step-off " Movimiento ocular restringido en el plano vertical (hacia arriba) Diplopía (ENAM EXTRA 2021)

Defecto pupilar aferente y alteración de la agudeza visual. Signo de lágrima en la radiografía.
deprimida del suelo orbitario derecho (fractura por estallido) se acompaña de una hernia de grasa orbitaria en la cara superior del seno maxilar y atrapamiento del músculo recto inferior (signo de la lagrima).

www.qxmedic.com PAG. 47 OFTALMOLOGÍA
FRONTAL ETMOIDES UNGUIS MAXILAR PALATINO CIGOMÁTICO ESFENOIDES
Figura 71. Los 7 huesos que forman parte de la órbita, recordar que la lámina papirácea forma parte del hueso etmoides
Figura 72. Fractura del piso o suelo orbitario Una fractura
Figura 73. Fractura del piso o suelo orbitario Prueba de motilidad ocular. La mirada hacia arriba del ojo derecho está restringida como resultado del atrapamiento del recto inferior.
TRATAMIENTO
Estabilización y reanimación urgentes Consulta oftalmológica inmediata por lesiones del globo ocular o síntomas vagales (Náuseas, vómitos, bradicardia)
Medidas conservadoras
♦ Profilaxis antibiótica (cuando hay comunicación con senos paranasales)
♦ Corticosteroides orales para reducir la hinchazón.

♦ Descongestionantes nasales y evitar sonarse la nariz (Para prevenir o evitar el empeoramiento del enfisema orbitario)
PARED MEDIAL O INTERNA
Enfisema periorbitario (ENAM 2004)
Movimiento ocular restringido en el plano horizontal → diplopía
PARED SUPERIOR
Perdida de líquido cefalorraquídeo
Neumoencefalo
Quemaduras químicas oculares
DEFINICIÓN
Quemadura química del ojo con compuestos ácidos (ácido sulfúrico, ácido clorhídrico) o alcalinos (cemento, lejía, yeso).
FISIOPATOLOGÍA
Ácidos → necrosis coagulativa (ENAM EXTRA 2020)

Álcalis → necrosis licuefactiva
DIAGNÓSTICO
Dolor intenso
Discapacidad visual
Blefaroespasmo: cierre involuntario de párpados.
Conjuntiva eritematosa o blanqueamiento de la conjuntiva
Fotofobia
TRATAMIENTO
Irrigación inmediata y completa con abundante solución salina estéril (preferiblemente si está disponible) o agua fría corriente. (ENAM EXTRA 2020)
Gotas oftálmicas antibióticas (Tetraciclina) + anestesia local
Consulta oftalmológica
Glucocorticoides tópicos (Acetato de prednisolona al 1%)
www.qxmedic.com OFTALMOLOGÍA PAG. 48
Figura 74. Opacificación corneal por quemadura química
Recuerda
EL cristalino deriva embriologicamente del ectodermo superficial
Epidemiología
Definición
La catarata es una condición caracterizada por la opacidad del cristalino del ojo.
Causa principal de ceguera reversible o curable
♦ Prevalencia de cataratas adquiridas: aumenta con la edad (80 años: 70%)
Sexo: ♀ > ♂
Etiología
Cataratas congénitas (<1%)
Cataratas congénitas hereditarias Causado por infecciones de TORCH (especialmente rubéola)

Asociado con las siguientes comorbilidades / síndromes:
♦ Galactosemia: Mancha en gota de aceite
♦ Tetania (hipocalcemia)
♦ Trisomía 21 (en la primera infancia)
♦ síndrome de Marfan
Examen con lámpara de hendidura del ojo izquierdo: Hay una opacificación blanca turbia de todo el cristalino. El reflejo rojo está ausente.

www.qxmedic.com PAG. 49
Figura 75. Catarata
Figura 76. Catarata en gota de aceite: galactosemia
CATARATA 11.
Cataratas adquiridas (> 99%)
Relacionado con la edad (> 90%): forma cortical es la más común. Como resultado de enfermedades oculares (catarata complicada)
♦ Diabetes mellitus: en copos de nieve
♦ Insuficiencia renal (diálisis)
♦ Enfermedad de Wilson Inducido por drogas
♦ Corticoides (locales y sistémicos): Subscapulares posterior
Etiología
Principalmente un diagnóstico clínico
Agudeza visual reducida: visión borrosa, nublada o tenue, especialmente de noche
La alteración de la visión suele ser indolora y, a menudo, bilateral
Destellos: asociado con halos alrededor de las luces
Una mejora temporal en la visión de cerca
Tratamiento
♦ Mióticas (inhibidores de colinesterasa) Consumo crónico de alcohol y tabaco
Traumático (catarata en roseta): más común en jóvenes (subcapsular anterior)
Condiciones relacionadas físicamente
♦ Radiación (rayos X, radiación radiactiva)


♦ Exposición excesiva a la luz solar o a los rayos UVB
♦ Radiación infrarroja (catarata del trabajador del vidrio)
Catarata traumática (catarata por contusión) Nublado subcapsular anterior, en forma de roseta del cristalino
(mejora la presbicia)
Oscurecimiento del reflejo rojo
En el caso de catarata congénita
♦ Leucocoria (pupila blanca)
♦ Estrabismo
♦ Nistagmo
♦ Retraso en el desarrollo de habilidades motoras
♦ Ambliopía por privación
Figura 78.
Leucocoria en un recién nacido: debemos descartar en primer lugar catarata congénita
Cirugía de elección: Facoemulsificación con colocación de lente intraocular

Complicaciones:
Intraoperatorio: ruptura de capsula posterior.
Postoperatoria: infecciones (endoftalmitis)
www.qxmedic.com OFTALMOLOGÍA PAG. 50
Figura 77.
12. DEFECTOS DE REFRACCIÓN (AMETROPÍAS)
Generalidades
La visión mejora con el uso del agujero estenopeico
Evaluación de la agudeza visual normal: 20/20 (cartilla de Snellen)

El niño alcanza la agudeza visual del adulto a los 4 años de edad.
Miopía
FISIOPATOLOGÍA:
Aumento anormal de la longitud axial del ojo (> 24 mm) o aumento de la refracción → punto focal antes de la retina
DIAGNÓSTICO
Visión de lejos borrosa y visión de cerca conservada
TRATAMIENTO
Anteojos con lentes cóncavos (negativos o divergentes) o cirugía refractiva (laser Excimer → LASIK)
COMPLICACIONES
Desprendimiento de retina regmatógena Glaucoma crónico o de ángulo abierto

www.qxmedic.com PAG. 51
Figura 79. Agujero estenopeico
Figura 80. Cartilla de Snellen
Hipermetropía
FISIOPATOLOGÍA
Recuerda
El recién nacido tiene visión hipermétrope debido a que la longitud axial del ojo es de 17 mm.
Longitud axial del ojo anormalmente disminuida (< 24 mm) → punto focal posterior a la retina

DIAGNÓSTICO
Visión cercana borrosa
Astenopatía acomodativa
Fondo de ojo: Pseudopapiledema
Astigmatismo
FISIOPATOLOGÍA
Curvatura anormal de la córnea (+ común) y/o del cristalino.
DIAGNÓSTICO
Visión borrosa a todas las distancias
TRATAMIENTO
Astigmatismo regular (2 puntos focales): lentes cilíndricas
Ojo normal La imagen se enfoca en la retina
Miopía
Ojo grande, las imágenes lejanas se enfocan por delante de la retina
Hupermetropía
Ojo corto, las imágenes se enfican por detrás de la retina
Astigmatismo
TRATAMIENTO
Anteojos con lentes convexos (positivos o convergentes) o cirugía refractiva
COMPLICACIONES
Glaucoma agudo o de ángulo cerrado Degeneración macular asociado a la edad

Astigmatismo irregular (> 2 puntos focales): lentes de contacto correctivos y cirugía refractiva
COMPLICACIONES:
El inicio temprano aumenta el riesgo de ambliopía
Longitud ocular Visión lejana
Visión cercana Punto focal Visión lejana borrosa
Se afecta más la visión cercana
Los ejes vertical y horizontal enfocan en distintos puntos
Enfoque desigual según eje
www.qxmedic.com OFTALMOLOGÍA PAG. 52
Figura 81. Tipos de ametropías o defectos de refracción
Presbicia
FISIOPATOLOGÍA
Disminución de la elasticidad del cristalino, la fuerza del músculo ciliar y la curvatura del cristalino, relacionada con la edad (> 45 años) → disminución de la acomodación del cristalino (visión cercana)

DIAGNÓSTICO
Similar a la hipermetropía
La miopía preexistente puede compensar temporalmente la presbicia, lo que conduce a una mejora de la visión cercana
TRATAMIENTO
Anteojos con lentes convexos o cirugía refractiva.
Ambliopía
DEFINICIÓN:
Disminución visual en uno o ambos ojos de tipo funcional debido a un trastorno de la visión del desarrollo durante la primera infancia.
FISIOPATOLOGÍA:
Uno o ambos ojos transmiten información visual deficiente o no coincidente al cerebro → el cerebro suprime la información de uno o ambos ojos → desuso del ojo → falta de estímulos visuales con subdesarrollo parcial de la corteza visual

CLASIFICACIÓN
Ambliopía por estrabismo (asimetría ocular)
Ambliopía refractiva (hipermetropía)
DIAGNÓSTICO
Recuerda
Se debe sospechar una afección subyacente grave (Tumor cerebral) en bebés con estrabismo, especialmente en presencia de hallazgos oculares adicionales como Leucocoria.
Ambliopía por privación (ptosis, cataratas, tumor)
Principal causa de ↓ agudeza visual en infantes (3 – 5 años)
TRATAMIENTO
Oclusión mecánica o farmacológica del ojo sano (para estimular al ojo enfermo).

www.qxmedic.com PAG. 53 OFTALMOLOGÍA
OJO NORMAL OJO CON AMBLIOPÍA U OJO VAGO ¿?
Figura 83. Ambliopía u “ojo perezoso es una asimetría funcional en la agudeza visual
Figura 82. En la presbicia existe una pérdida de la acomodación del cristalino para la visión cercana
13. TUMORES ORBITARIOS PRIMARIOS
Hemangioma capilar
GENERALIDADES
Los hemangiomas capilares son el tumor orbitario benigno más común en los niños Más del 90% se manifiesta antes de los 6 meses.
Tienden a agrandarse rápidamente en el primer año de vida y retroceden lentamente en el transcurso de 6 a 7 años.
DIAGNÓSTICO
Las lesiones superficiales que afectan al párpado son de color rojizo (nevus en fresa)
Las lesiones dentro de la órbita pueden causar estrabismo, proptosis o neuropatía óptica compresiva.

La afectación de los párpados puede inducir astigmatismo u obstruir la visión, lo que resulta en ambliopía.
Hemangioma capilar con afectación cutánea y orbitaria del lado derecho que resulta en endotropía.

TRATAMIENTO:
Los esteroides sistémicos o intralesionales fueron la terapia estándar de primera línea. Un betabloqueante sistémico, típicamente propranolol, también es eficaz.
La cirugía generalmente se reserva para casos refractarios o con compromiso visual.
Hemangioma cavernoso
GENERALIDADES
El tumor orbitario benigno más común en adultos
Ocurren con mayor frecuencia en mujeres no tienden a retroceder espontáneamente
DIAGNÓSTICO
produciendo proptosis axial, hipermetropía y pliegues coroideos.
TRATAMIENTO
La escisión quirúrgica suele tener éxito y está indicada si el paciente presenta síntomas.
Alternativa: radioterapia
www.qxmedic.com PAG. 55
Figura 84.
Figura 85. Imagen de resonancia magnética axial del hemangioma cavernoso intraconal de la órbita izquierda colindante con el nervio óptico.
Rabdomiosarcoma
GENERALIDADES
Tumor orbitario maligno primario más común en la niñez. La presentación es antes de los 10 años
DIAGNÓSTICO
El crecimiento rápido es característico con proptosis y / o desplazamiento hacia abajo del globo ocular, ya que dos tercios de estos tumores se localizan en la órbita supero nasal
El tumor puede destruir el hueso orbitario adyacente y diseminarse al cerebro.
TRATAMIENTO
El tratamiento depende de la estadificación e incluye cirugía, quimioterapia y / o radioterapia.
Neurofibroma
GENERALIDADES
La neurofibromatosis tipo 1 (NF1) (enfermedad de von Recklinghausen) es una enfermedad hereditaria autosómica dominante debida a mutaciones en el cromosoma 17q.


DIAGNÓSTICO
Los neuro fibromas plexiformes son característicos y pueden distorsionar los párpados y desfigurar la órbita
La presencia de nódulos de Lisch en el iris y manchas cutáneas café con leche ayuda a confirmar el diagnóstico.
El quince por ciento de los pacientes puede desarrollar un glioma del nervio óptico que puede manifestarse como proptosis y / o pérdida visual.
Algunos de estos pacientes también desarrollan meningiomas

www.qxmedic.com OFTALMOLOGÍA PAG. 56
Figura 86. Rabdomiosarcoma de la órbita derecha
Figura 87. Resonancia magnética coronal que muestra tumoración en la órbita supero nasal (flecha)
Tumores de glándula lacrimal
El 50% de las masas de la glándula lagrimal son tumores epiteliales
El tumor epitelial benigno más común es el adenoma pleomórfico (tumor mixto benigno)
♦ Bien encapsulados, sin destrucción ósea
♦ Debe extirparse, no biopsias, debido a su propensión a la recurrencia y la transformación maligna. De los tumores epiteliales malignos de la glándula lagrimal, el 60% está compuesto por carcinoma quístico adenoide
♦ Lesiones mal definidas con áreas de calcificación
♦ Típicamente se presenta con dolor, proptosis no axial y cambios óseos destructivos de la fosa supero temporal en la TC.
♦ La biopsia debe realizarse a través del párpado para evitar la diseminación del tumor en la órbita.
Tumores orbitarios metastásicos
Los tumores metastásicos llegan a la órbita por diseminación hematógena.

En los adultos, el cáncer de mama, pulmón, próstata y el melanoma son los tumores primarios habituales.
En los niños, el tumor metastásico más común es el neuroblastoma
Los tumores metastásicos son mucho más frecuentes en la coroides que en la órbita, probablemente debido a la naturaleza del riego sanguíneo.
Tumores intraoculares primarios
RETINOBLASTOMA


GENERALIDADES
Tumor intraocular maligno primaria más común en los niños
Edad de inicio: <4 años
El gen del retinoblastoma (RB1) es un gen supresor de tumores que se encuentra en el cromosoma 13.
♦ Esporádicos: mutación espontanea (unilaterales) 95% casos
♦ Hereditarios: herencia autosómica dominante (son bilaterales) 5 % casos
www.qxmedic.com PAG. 57 OFTALMOLOGÍA
Figura 88. Neurofibroma plexiforme que afecta la cara, los párpados y la órbita izquierdos en la neurofibromatosis tipo 1.
Figura 89. Nódulos de Lisch en el iris en un paciente con neurofibromatosis tipo 1.
Recuerda
Los pacientes con mutaciones hereditarias del gen Rb también tienen un riesgo significativamente mayor de desarrollar osteosarcomas y pinealomas.

Recuerda
El estrabismo es normal hasta tres meses después del nacimiento. El estrabismo que persista después de tres meses debe ser evaluado por un oftalmólogo.
Durante el examen oftalmológico, la prueba de cubrir un ojo (cover test), sirve para determinar el estrabismo latente (forias)
PATOLOGÍA
Deriva de las neuronas bipolares
En la forma diferenciada, es posible observar las rosetas de Flexner-Wintersteiner o fleurette compuestas por células muy maduras, cúbicas o cilíndricas, bajas dispuestas alrededor de una luz central.
Figura 90. Retinoblastoma que muestra las rosetas de Flexneri – Winter Steiner (también son vistos en Ependimoma y pinealoblastoma)


DIAGNÓSTICO
Leucocoria
Estrabismo (1 a 2 años)(ENAM 2020)
Proptosis (ENAM 2020)
Defecto pupilar aferente (pupila de Marcus Gunn) (ENAM 2020)
Un ojo rojo y doloroso (pseudouveitis o glaucoma secundario)

Desprendimiento de retina exudativo
Examen del fondo de ojo: tumor retiniano vascularizado de color blanco grisáceo Ecografía ocular: Masa intraocular irregular que es hiperecogénica y tiene focos de sombra acústica (debido a calcificaciones)
Resonancia magnética del cráneo con contraste: identifique la afectación del nervio óptico y la extensión del tumor
Debe evitarse la tomografía computarizada debido al riesgo de tumores inducidos por radiación en pacientes con mutación RB1
Las biopsias de retinoblastomas están contraindicadas debido al riesgo de diseminación tumoral.
El
(leucocoria
www.qxmedic.com OFTALMOLOGÍA PAG. 58
Figura 92. Dos tumores de retinoblastoma intraretinianas discretos en el ojo izquierdo de un niño con retinoblastoma bilateral.
Figura 91. Leucocoria. Paciente con retinoblastoma.
ojo izquierdo muestra el reflejo retiniano normal, mientras que la pupila derecha aparece blanca
TRATAMIENTO
Si el ojo es potencialmente recuperable: Retinoblastomas de bajo riesgo
♦ Crioterapia
♦ Fotocoagulación

♦ Braquiterapia
Retinoblastomas de alto riesgo: quimioterapia Si el ojo no se puede salvar (ya sea anatómica o funcionalmente)

Enucleación: implica la extirpación completa del globo ocular, junto con una parte del nervio óptico.
Quimioterapia sistémica y / o radioterapia adyuvante En el caso de enfermedad metastásica: quimioterapia de dosis alta con / sin radioterapia
MELANOMA DE COROIDES
GENERALIDADES
Los tumores intraoculares más frecuentes son las metástasis coroideas de tumores sistémicos (pulmón en el hombre y mama en la mujer).
El melanoma de coroides constituye el tumor maligno intraocular primario más frecuente en el adulto.
Casi siempre es unilateral y unifocal.
PATOLOGÍA
Mixto: Células fusiformes y epitelioides. Son los más frecuentes y pronóstico intermedio.
Células fusiformes: Los de mejor pronóstico
Epitelioide: Los de peor pronóstico
DIAGNÓSTICO
Tumor sobreelevado, pigmentado y unilateral.
Afecta campo visual y acompañarse de desprendimiento de retina (exudativo).
Puede diseminarse por extensión directa, dar metástasis locales y metástasis sistémicas (más frecuente hígado).
Fondo de ojo: masa subretiniana de color marrón oscuro a dorado pálido
TRATAMIENTO
Lesiones pequeñas y poco elevadas: fotocoagulación o radioterapia con placa de yodo-125
Cirugía: Resección local, crioterapia, enucleación
Si hay metástasis: Tratamiento paliativo (quimioterapia e ¡inmunoterapia).
www.qxmedic.com PAG. 59 OFTALMOLOGÍA
Figura 93. Fondo de ojo de un paciente con melanoma de coroides